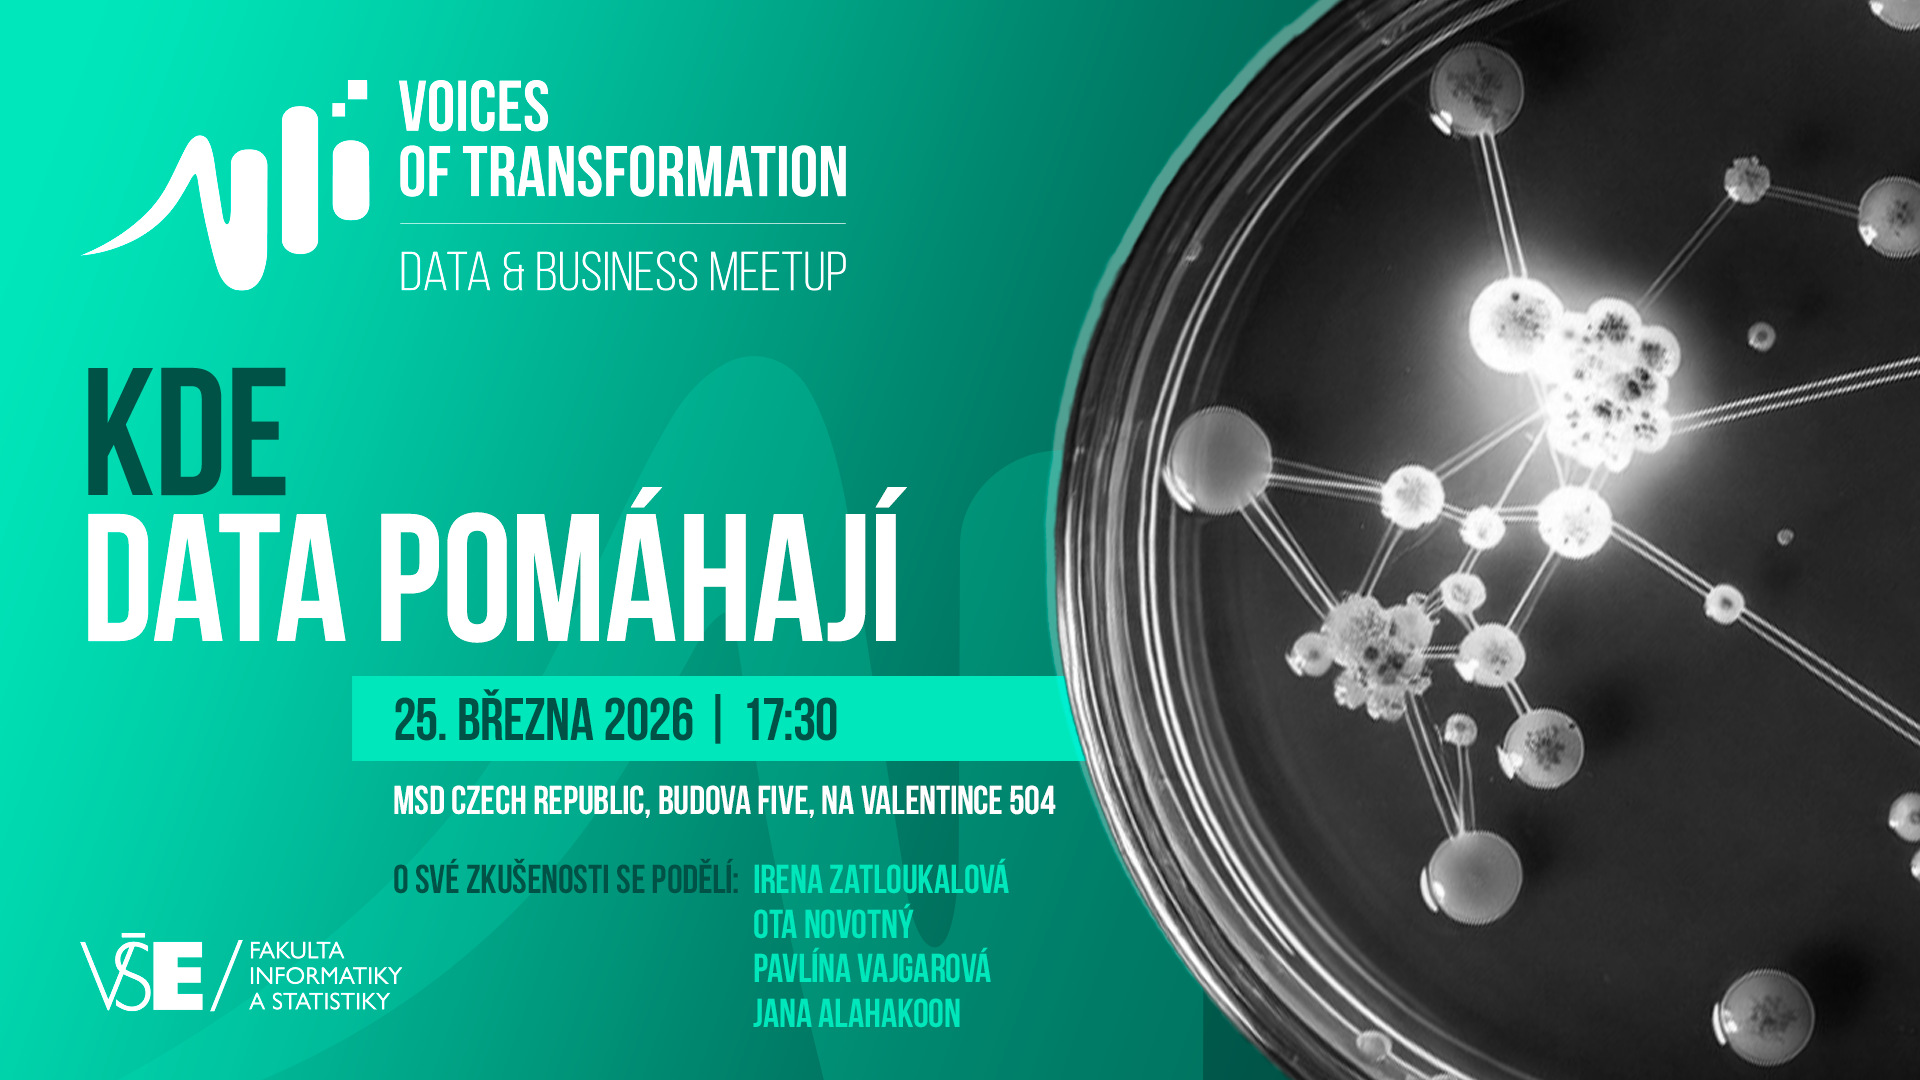
Kde data pomáhají

Kde data pomáhají? Přijďte to zjistit na další meetup ze série Voices of Transformation
Jak mohou data pomáhat lidem, organizacím i celé společnosti? A jak s nimi pracovat citlivě, eticky a udržitelně?
Přijďte na další veřejné setkání ze série Voices of Transformation, kde společně propojíme komunitu kolem Fakulty informatiky a statistiky VŠE v Praze a MSD Czech Republic s lidmi z neziskového sektoru, akademické sféry i byznysu. Společně budeme hledat odpověď na otázku, kde už dnes data přinášejí reálný společenský dopad – a kde naopak narážíme na limity, rizika nebo etická dilemata.
Večer otevřou krátké prezentace z různých prostředí a oborů. Uslyšíte konkrétní příklady toho, jak lze data využívat pro veřejně prospěšné projekty či inovace ve zdravotnictví, i jak můžete transformovat svou kariéru díky datovému vzdělání.
Krátké příspěvky nabídnou:
- Pavlína Vajgarová (konference Dobrodata) – Kde data pomáhají
- Ota Novotný (FIS VŠE) – Data pro budoucí generace
- Irena Zatloukalová (Diversight) – Datařina na spektru
- Jana Alahakoon (MSD) – Jak zdravotní data pomáhají pacientům
Na prezentace naváže panelová diskuse, která otevře otázky etiky, souhlasu a ochrany dat. Zaměříme se také na praktickou stránku práce s daty – jak je sbírat, interpretovat a sdílet tak, aby skutečně pomáhala lidem i organizacím.
Na závěr nebude chybět prostor pro neformální networking, kde budete mít možnost potkat další lidi z datové komunity a dozvědět se více také o našich MBA programech zaměřených na datovou analytiku a IT management.
Setkání se uskuteční 25. března 2026 od 17:30 do 20:00 v prostorách MSD Five Auditorium, Na Valentince 504, Praha 5.
Účast na akci je zdarma po předchozí registraci na tomto odkazu.
Těšíme se na vás.
